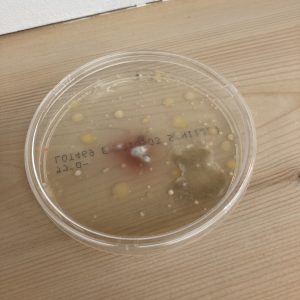

2021年12月12日
ツナガリズム。
気持ちがいい土曜日。事務所にて事務作業を行う。ジャケットやネクタイを纏わないラフなスタイルなので気分は軽い。まちなかは群馬県の県域ラジオ局、FMぐんま主催の「ツナガリズム祭り」で大賑わいだった。県域局の影響力を実感する。
昼食がてらまちをぶらつくと様々な人たちと出会うことができるのもこう言ったイベントの醍醐味である。いつもいくまちなかの中華料理屋「風雷」にて坦々麺をいただきながら市政へのご意見もいただく。
□本日のめぶき 「流れを掴む」
前橋まちなかを流れる2つの川の流域で行われているアートフェス、「River to River 川のほとりのアートフェス」。初日に回りきれなかった展示場所を空き時間で回る。
まちなかのギャラリーmapにて展示されている山口貴子氏の作品。捕まえられない川の流れの中にも在るものがある。
前橋市議会議員 岡 正己



